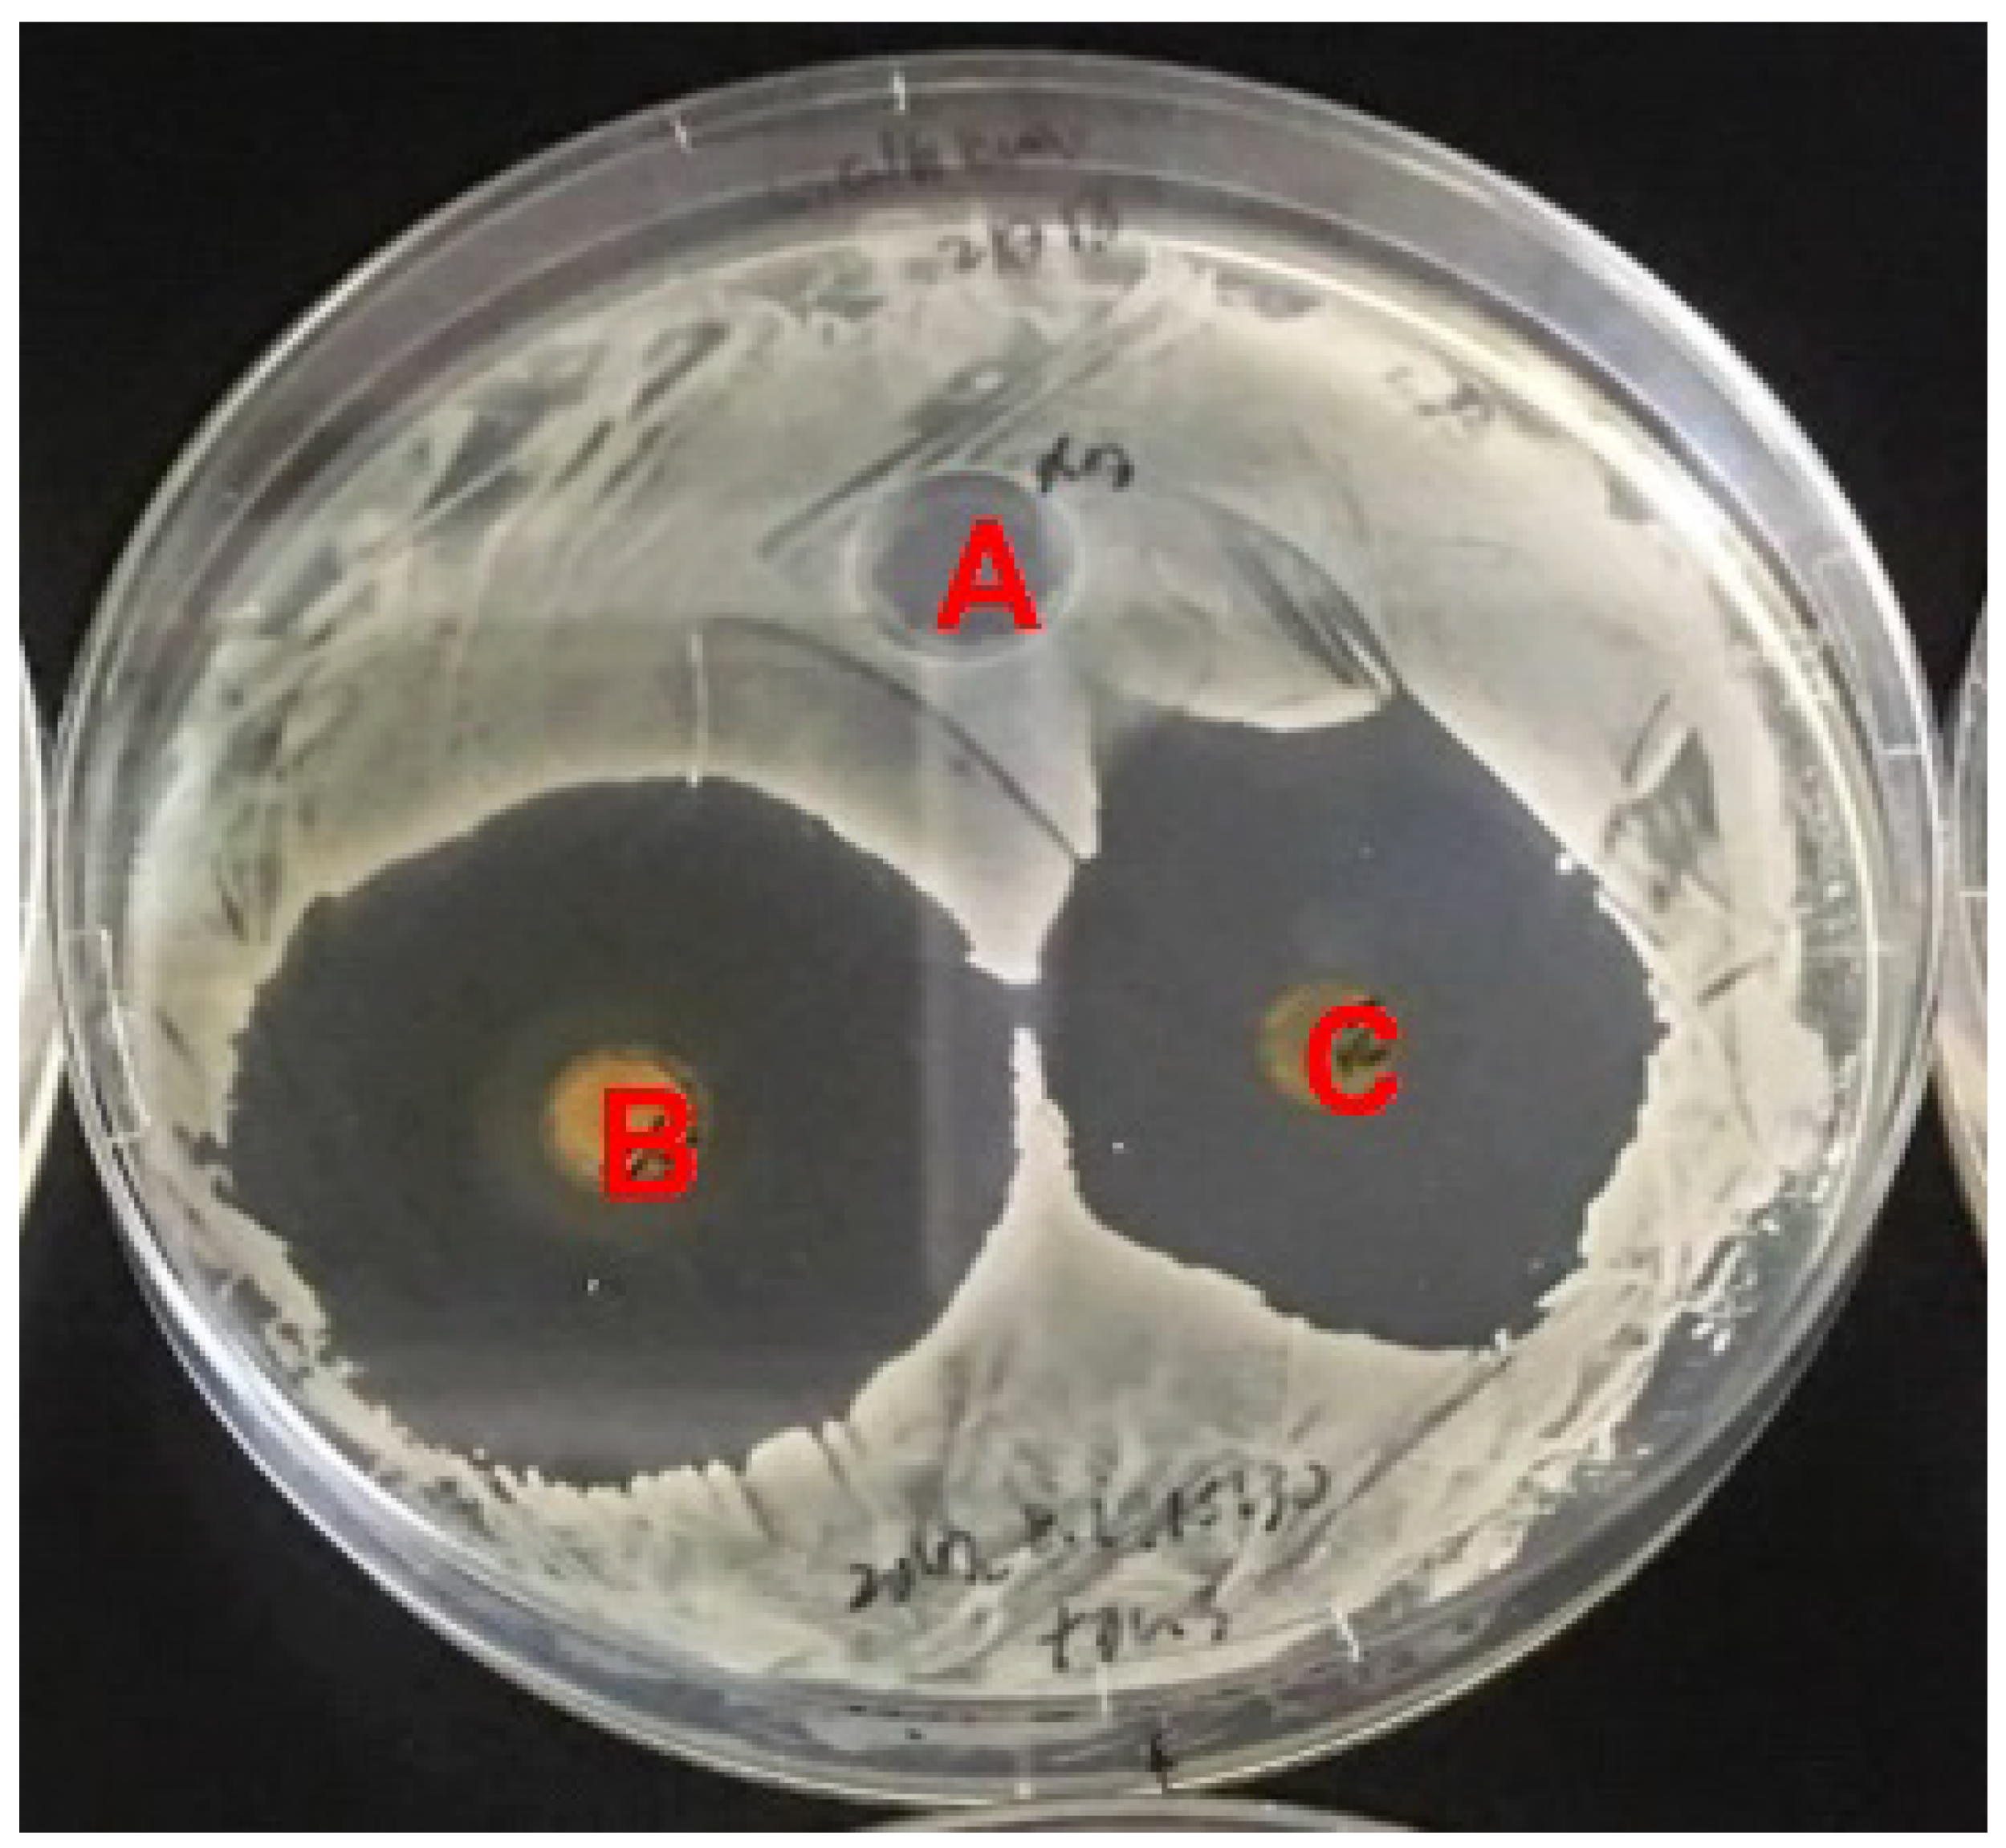
Microorganisms 10 00037 g001 Microorganisms 10 00037 g001

Genome Sequence-Guided Finding of Lucensomycin Production by Streptomyces achromogenes Subsp. streptozoticus NBRC14001
Abstract
1. Introduction
2. Materials and Methods
2.1. Strains and Culture Conditions
2.2. Genome Sequencing and In Silico Analysis
2.3. Pilot Antifungal Activity Test
2.4. Isolation of an Antifungal Compound
2.5. HPLC Analysis of a Purified Antifungal Compound
2.6. ESI-MS and MS/MS Spectrometry
3. Results
3.1. The Genome-Guided Approach Revealed That Strain NBRC14001 Produces Compound(s) That Exhibit Antifungal Activity
3.2. The Active Compound Exhibiting Antifungal Activity Is Different from NTM
3.3. Structural Analysis of the Antifungal Compound
3.4. Verification of LCM Production by Comparisons of BGCs
4. Discussion
5. Conclusions
Supplementary Materials
Author Contributions
Funding
Institutional Review Board Statement
Informed Consent Statement
Data Availability Statement
Acknowledgments
Conflicts of Interest
References
- Demain, A.L.; Sanchez, S. Microbial drug discovery: 80 years of progress. J. Antibiot. 2009, 62, 5–16. [Google Scholar] [CrossRef]
- Takahashi, Y.; Omura, S. Isolation new actinomycete strains for the screening of new bioactive compounds. J. Gen. Appl. Microbiol. 2003, 49, 141–154. [Google Scholar] [CrossRef] [PubMed]
- Blin, K.; Shaw, S.; Kloosterman, A.M.; Charlop-Powers, Z.; von Wenzel, G.P.; Medema, M.H.; Weber, T. antiSMASH 6.0: Improving cluster detection and comparison capabilities. Nucl. Acids Res. 2021, 49, W29–W35. [Google Scholar] [CrossRef]
- Singh, T.A.; Passari, A.K.; Jajoo, A.; Bhasin, S.; Gupta, V.K.; Hashem, A.; Alqarawi, A.A.; Allah, E.F.A. Tapping into actinobacterial genome for natural product discovery. Front. Microbiol. 2021, 12, 655620. [Google Scholar] [CrossRef] [PubMed]
- Kang, H.-S.; Kim, E.-S. Recent advances in heterologous expression of natural product biosynthetic gene clusters in Streptomyces hosts. Curr. Opin. Biotechnol. 2021, 69, 118–127. [Google Scholar] [CrossRef]
- Liu, L.L.; Jiang, W.; Lu, Y. Recent advances in synthetic biology approaches to optimize production of bioactive natural products in actinobacteria. Front. Microbiol. 2019, 10, 2467. [Google Scholar] [CrossRef] [PubMed]
- Lee, N.; Hwang, S.; Kim, J.; Cho, S.; Palsson, B.; Cho, B.-K. Genome mining approaches for the identification of secondary metabolite biosynthetic gene clusters in Streptomyces. Comput. Struct. Biotechnol. J. 2020, 18, 1548–1556. [Google Scholar] [CrossRef]
- Vavra, J.J.; Deboer, C.; Dietz, A.; Hanka, L.J.; Sokolski, W.T. Streptozotocin, a new antibacterial antibiotic. Antibiot. Annu. 1959–1960, 7, 230–235. [Google Scholar]
- Herr, R.R.; Eble, T.E.; Bergy, M.E.; Jahnke, H.K. Isolation and characterization of streptozotocin. Antibiot. Annu. 1959–1960, 7, 236–240. [Google Scholar]
- Sokolski, W.T.; Vavra, J.J.; Hanka, L.J. Assay methods and antibacterial studies on streptozotocin. Antibiot. Annu. 1959–1960. 7, 241–246.
- Kiesewetter, B.; Raderer, M. How I treat neuroendocrine tumors. ESMO Open 2020, 5, e000811. [Google Scholar] [CrossRef]
- Aparicio, J.F.; Colina, A.J.; Ceballos, E.; Martin, J.F. The biosynthetic gene cluster for the 26-memberd ring polyene macrolide pimaricin. A new polyketide synthase organization encoded by two subclusters separated by functionalization genes. J. Biol. Chem. 1999, 274, 10133–10139. [Google Scholar] [CrossRef]
- Hamilton-Miller, J.M.T. Chemistry and biology of the polyene macrolide antibiotics. Bacteriol. Rev. 1973, 37, 166–196. [Google Scholar] [CrossRef]
- Kim, J.D.; Kang, J.E.; Kim, B.S. Postharvest disease control efficacy of the polyene macrolide lucensomycin produced by Streptomyces plumbeus strain CA5 against gray mold on grapes. Postharvest Biol. Technol. 2020, 162, 111115. [Google Scholar] [CrossRef]
- Kieser, T.; Bibb, M.J.; Buttner, M.J.; Chater, K.F.; Hopwood, D.A. Practical Streptomyces Genetics; The John Innes Foundation: Norwich, UK, 2000. [Google Scholar]
- Chin, C.S.; Alexander, D.H.; Marks, P.; Klammer, A.A.; Drake, J.; Heiner, C.; Clum, A.; Copeland, A.; Huddleston, J.; Eichler, E.E.; et al. Nonhybrid, finished microbial genome assemblies from long-read SMRT sequencing data. Nat. Methods 2013, 10, 563–569. [Google Scholar] [CrossRef]
- Seemann, T. Prokka: Rapid prokaryotic genome annotation. Bioinformatics 2014, 30, 2068–2069. [Google Scholar] [CrossRef] [PubMed]
- Sakurai, N.; Ara, T.; Kanaya, S.; Nakamura, Y.; Iijima, Y.; Enomoto, M.; Motegi, T.; Aoki, K.; Suzuki, H.; Shibata, D. An application of a relational database system for high-throughput prediction of elemental compositions from accurate mass values. Bioinformatics 2013, 29, 290–291. [Google Scholar] [CrossRef]
- Kim, S. Exploring chemical information in PubChem. Curr. Protoc. 2021, 1, e217. [Google Scholar] [CrossRef] [PubMed]
- Yushchuk, O.; Ostash, I.; Mösker, E.; Vlasiuk, I.; Deneka, M.; Rückert, C.; Busche, T.; Fedorenko, V.; Kalinowski, J.; Süssmuth, R.D.; et al. Eliciting the silent lucensomycin biosynthetic pathway in Streptomyces cyanogenus S136 via manipulation of the global regulatory gene adpA. Sci. Rep. 2021, 11, 3507. [Google Scholar] [CrossRef]
- Altschul, S.F.; Gish, W.; Miller, W.; Myers, E.W.; Lipman, D.J. Basic local alignment search tool. J. Mol. Biol. 1990, 215, 403–410. [Google Scholar] [CrossRef]
- Struyk, A.P.; Hoette, I.; Drost, G.; Waisvisz, J.M.; Van Eek, T.; Hoogerheide, J.C. Pimaricin, a new antifungal antibiotic. Antibiot. Annu. 1957–1958. 5, 878–885.
- Zhou, Y.; Meng, Q.; You, D.; Li, J.; Chen, S.; Zhou, X.; Zhou, H.; Bai, L.; Deng, Z. Selective removal of aberrant extender units by a type II thioesterase for efficient FR-008/candicidin biosynthesis in Streptomyces sp. Strain FR-008. Appl. Environ. Microbiol. 2008, 74, 7235–7242. [Google Scholar] [CrossRef]
- Mendes, M.V.; Antón, N.; Martín, J.F.; Aparicio, J.F. Characterization of the polyene macrolide P450 epoxidase from Streptomyces natalensis that converts de-epoxypimaricin into pimaricin. Biochem. J. 2005, 386, 57–62. [Google Scholar] [CrossRef] [PubMed][Green Version]
- Antón, N.; Mendes, M.V.; Martín, J.F.; Aparicio, J.F. Identification of PimR as a positive regulator of pimaricin biosynthesis in Streptomyces natalensis. J. Bacteriol. 2004, 186, 2567–2575. [Google Scholar] [CrossRef] [PubMed]
- Antón, N.; Santos-Aberturas, J.; Mendes, M.V.; Guerra, S.M.; Martín, J.F.; Aparicio, J.F. PimM, a PAS domain positive regulator of pimaricin biosynthesis in Streptomyces natalensis. Microbiology 2007, 153, 3174–3183. [Google Scholar] [CrossRef] [PubMed]
- Sekurova, O.N.; Brautaset, T.; Sletta, H.; Borgos, S.E.F.; Jacobsen, Ø.M.; Ellingsen, T.E.; Strøm, A.R.; Valla, S.; Zotchev, S.B. In vivo analysis of the regulatory genes in the nystatin biosynthetic gene cluster of Streptomyces noursei ATCC11445 reveals their different control over antibiotic biosynthesis. J. Bacteriol. 2004, 186, 1345–1354. [Google Scholar] [CrossRef] [PubMed]
- Ohnishi, Y.; Yamazaki, H.; Kato, J.Y.; Tomono, A.; Horinouchi, S. AdpA, a central transcriptional regulator in the A-factor regulatory cascade that leads to morphological development and secondary metabolism in Streptomyces griseus. Biosci. Biotechnol. Biochem. 2005, 69, 431–439. [Google Scholar] [CrossRef] [PubMed]

| ORF | aa | Putative Protein | Lcm Homolog | Identity /Positivity (%) |
|---|---|---|---|---|
| Luc2 | 344 | GDP-D-mannose 4,6-dehydratase | Lcm2 | 94/97 |
| Luc3 | 257 | Type II thioesterase | Lcm3 | 86/91 |
| LucA | 3035 | Type I polyketide synthase (module 0–1) | LcmA | 90/93 |
| LucB | 6457 | Type I polyketide synthase (module 2–5) | LcmB | 87/91 |
| Luc4 | 469 | GDP-mycosamine glycosyltransferase | Lcm4 | 82/90 |
| Luc5 | 352 | GDP-3-keto-6-deoxy-D-mannose C-3 aminotransferase | Lcm5 | 73/83 |
| Luc6 | 392 | Cytochrome P450 monooxygenase | Lcm6 | 92/97 |
| Luc7 | 64 | Ferredoxin | Lcm7 | 88/93 |
| LucC | 9249 | Type I polyketide synthase (module 6–11) | LcmC | 91/94 |
| LucD | 1789 | Type I polyketide synthase (module 12) | LcmD | 90/93 |
| LucE | 1995 | Type I polyketide synthase (module 13) | LcmE | 91/94 |
| Luc8 | 578 | ABC transporter | Lcm8 | 90/93 |
| Luc9 | 625 | ABC transporter | Lcm9 | 89/93 |
| Luc10 | 386 | Cytochrome P450 monooxygenase | Lcm10 | 90/94 |
| LucRI | 204 | HTH-LuxR domain-containing transcriptional regulator | LcmRI | 83/90 |
| LucRII | 230 | HTH-LuxR domain-containing transcriptional regulator | LcmRII | 83/89 |
| Luc11 | 548 | Cholesterol oxidase | Lcm11 | 91/95 |
| Luc12 | 100 | Hypothetical protein | ||
| LucRIII | 1188 | Transcriptional regulator | LcmRIII | 82/86 |
| Cluster | PKS | Module | Domain Structure |
|---|---|---|---|
| luc cluster | |||
| LucA | 0 | KS-AT-ACP | |
| 1 | KS-AT-DH-ER-KR-ACP | ||
| LucB | 2 | KS-AT-KR-ACP | |
| 3 | KS-AT-DH-KR-ACP | ||
| 4 | KS-AT-DH-KR-ACP | ||
| 5 | KS-AT-DH-KR-ACP | ||
| LucC | 6 | KS-AT-DH-KR-ACP | |
| 7 | KS-AT-KR-ACP | ||
| 8 | KS-AT-KR-ACP | ||
| 9 | KS-AT-KR-ACP | ||
| 10 | KS-AT-ACP | ||
| 11 | KS-AT-KR-ACP | ||
| LucD | 12 | KS-AT-DH-KR-ACP | |
| LucE | 13 | KS-AT-DH-KR-ACP-TE | |
| lcm cluster | |||
| LcmA | 0 | KS-AT-ACP | |
| 1 | KS-AT-DH-ER-KR-ACP | ||
| LcmB | 2 | KS-AT-KR-ACP | |
| 3 | KS-AT-DH-KR-ACP | ||
| 4 | KS-AT-DH-KR-ACP | ||
| 5 | KS-AT-DH-KR-ACP | ||
| LcmC | 6 | KS-AT-DH-KR-ACP | |
| 7 | KS-AT-KR-ACP | ||
| 8 | KS-AT-KR-ACP | ||
| 9 | KS-AT-KR-ACP | ||
| 10 | KS-AT-ACP | ||
| 11 | KS-AT-KR-ACP | ||
| LcmD | 12 | KS-AT-DH-KR-ACP | |
| LcmE | 13 | KS-AT-DH-KR-ACP-TE |
Publisher’s Note: MDPI stays neutral with regard to jurisdictional claims in published maps and institutional affiliations. |
© 2021 by the authors. Licensee MDPI, Basel, Switzerland. This article is an open access article distributed under the terms and conditions of the Creative Commons Attribution (CC BY) license (https://creativecommons.org/licenses/by/4.0/).
Share and Cite
Nishimura, S.; Nakamura, K.; Yamamoto, M.; Morita, D.; Kuroda, T.; Kumagai, T. Genome Sequence-Guided Finding of Lucensomycin Production by Streptomyces achromogenes Subsp. streptozoticus NBRC14001. Microorganisms 2022, 10, 37. https://doi.org/10.3390/microorganisms10010037
Nishimura S, Nakamura K, Yamamoto M, Morita D, Kuroda T, Kumagai T. Genome Sequence-Guided Finding of Lucensomycin Production by Streptomyces achromogenes Subsp. streptozoticus NBRC14001. Microorganisms. 2022; 10(1):37. https://doi.org/10.3390/microorganisms10010037
Chicago/Turabian StyleNishimura, Sho, Kazune Nakamura, Miyako Yamamoto, Daichi Morita, Teruo Kuroda, and Takanori Kumagai. 2022. "Genome Sequence-Guided Finding of Lucensomycin Production by Streptomyces achromogenes Subsp. streptozoticus NBRC14001" Microorganisms 10, no. 1: 37. https://doi.org/10.3390/microorganisms10010037
APA StyleNishimura, S., Nakamura, K., Yamamoto, M., Morita, D., Kuroda, T., & Kumagai, T. (2022). Genome Sequence-Guided Finding of Lucensomycin Production by Streptomyces achromogenes Subsp. streptozoticus NBRC14001. Microorganisms, 10(1), 37. https://doi.org/10.3390/microorganisms10010037
